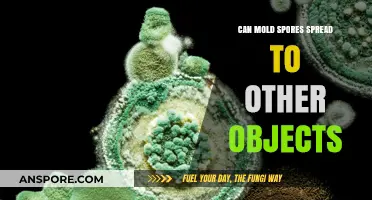
How Mold Spores Travel: Can They Contaminate Other Objects?

Mold spores are known for their resilience and ability to survive in various environments, but their fate during fermentation processes, particularly in flour, remains a subject of interest. Fermentation, a metabolic process driven by microorganisms, can create conditions that may either inhibit or support the survival of mold spores. In the context of flour, which is often used in fermented foods like bread and sourdough, understanding whether mold spores can endure this transformation is crucial for food safety and quality. The acidic environment and microbial competition during fermentation could potentially suppress mold growth, yet some spores might possess mechanisms to withstand these challenges, raising questions about their persistence and the implications for both artisanal and industrial food production.
| Characteristics | Values |
|---|---|
| Survival of Mold Spores | Mold spores in flour can survive the fermentation process. |
| Heat Resistance | Mold spores are generally heat-resistant and can withstand temperatures typically used in fermentation (around 30-40°C or 86-104°F). |
| pH Tolerance | Mold spores can tolerate a wide range of pH levels, including the slightly acidic environment created during fermentation. |
| Oxygen Requirement | Mold spores can survive in both aerobic (with oxygen) and anaerobic (without oxygen) conditions, though they may remain dormant in anaerobic environments. |
| Moisture Dependency | Mold spores require moisture to germinate, but they can remain dormant in dry conditions, such as in flour, until favorable conditions return. |
| Fermentation Impact | Fermentation does not typically eliminate mold spores; it may inhibit their growth temporarily but does not kill them. |
| Storage Implications | Proper storage of fermented products is crucial to prevent mold spore germination and growth, especially in humid conditions. |
| Health Risks | Surviving mold spores in fermented products can pose health risks if consumed, particularly for individuals with mold allergies or weakened immune systems. |
| Prevention Methods | Using fresh, high-quality flour and maintaining proper hygiene during fermentation can reduce the risk of mold spore contamination. |
Explore related products
What You'll Learn

Effect of Fermentation Temperature on Mold Spores
Fermentation temperature plays a critical role in determining the fate of mold spores in flour. While some mold species can withstand the acidic and anaerobic conditions of fermentation, temperature acts as a pivotal factor in their survival. Generally, mold spores exhibit higher resistance to heat compared to their vegetative forms, but prolonged exposure to specific temperature ranges can significantly reduce their viability. Understanding this relationship is essential for optimizing fermentation processes to minimize mold contamination in food products.
Analyzing the Temperature Spectrum:
At temperatures below 20°C (68°F), fermentation slows, and mold spores may remain dormant or even proliferate if conditions are favorable. This is particularly concerning in sourdough fermentation, where cooler temperatures are often used to develop flavor. Between 25°C and 35°C (77°F–95°F), most lactic acid bacteria and yeast thrive, creating an environment that can inhibit mold growth through competition and pH reduction. However, temperatures above 40°C (104°F) can denature proteins and enzymes in mold spores, effectively killing them. For instance, studies show that exposure to 50°C (122°F) for 30 minutes reduces mold spore viability by over 90% in flour-based mediums.
Practical Steps for Mold Control:
To leverage temperature for mold suppression, maintain fermentation at 30°C–35°C (86°F–95°F) for optimal microbial activity while discouraging mold. For sourdough starters, use a heating pad or proofing box to stabilize temperature. If mold is detected, discard the contaminated portion and restart the fermentation at a higher temperature to ensure spore inactivation. Additionally, pre-fermenting flour at 50°C (122°F) for 30 minutes before use can eliminate spores without affecting dough quality.
Cautions and Limitations:
While temperature is a powerful tool, it is not foolproof. Some mold species, like *Aspergillus* and *Penicillium*, produce heat-resistant spores that may survive moderate fermentation temperatures. Overheating can also degrade flour proteins, affecting dough structure. Always monitor fermentation closely and combine temperature control with other strategies, such as proper hygiene and humidity management, for comprehensive mold prevention.
Fermentation temperature is a double-edged sword in the battle against mold spores. By strategically manipulating temperature within the 30°C–50°C range, you can create an environment hostile to mold while fostering beneficial microbial activity. However, success depends on precision and awareness of mold species' resilience. Incorporate temperature control as part of a holistic approach to ensure safe, mold-free fermentation in flour-based products.
Can Aerobes Form Spores? Unveiling Microbial Survival Strategies
You may want to see also

Role of Yeast in Inhibiting Mold Growth
Yeast, a microscopic fungus, plays a pivotal role in fermentation processes, particularly in baking and brewing. Beyond its ability to leaven dough or produce alcohol, yeast also acts as a natural inhibitor of mold growth. This is crucial in environments where flour, a common mold spore carrier, is used. During fermentation, yeast competes with mold for resources, primarily sugars, and produces byproducts that create an unfavorable environment for mold proliferation. This competitive exclusion principle is a cornerstone of yeast’s inhibitory role, making it an essential ally in food preservation.
To harness yeast’s mold-inhibiting properties effectively, specific conditions must be met. Optimal fermentation requires a temperature range of 24–30°C (75–86°F) and a pH level between 4.0 and 6.0. At these conditions, yeast thrives, outcompeting mold spores for nutrients and producing ethanol and organic acids, such as acetic and lactic acids, which are toxic to mold. For instance, adding 2–3% active dry yeast to flour-based mixtures can significantly reduce mold growth during the initial stages of fermentation. However, improper yeast dosage or unfavorable conditions may render this method ineffective, underscoring the need for precision.
A comparative analysis of yeast and mold reveals why yeast often emerges victorious in their ecological battle. Mold spores, while resilient, require oxygen and moisture to germinate and grow. Yeast, being anaerobic during fermentation, depletes oxygen levels, creating an environment hostile to mold. Additionally, yeast’s rapid consumption of sugars leaves mold with insufficient nutrients to thrive. This dual mechanism—oxygen depletion and nutrient competition—positions yeast as a formidable antagonist to mold in fermented products.
Practical applications of yeast’s mold-inhibiting properties extend beyond traditional baking. In sourdough bread-making, for example, wild yeast and lactic acid bacteria work synergistically to suppress mold. Maintaining a sourdough starter at a 1:1:1 ratio of flour, water, and starter, with regular feedings every 12–24 hours, ensures a robust yeast population. Similarly, in brewing, the addition of yeast during fermentation not only converts sugars into alcohol but also prevents mold contamination, ensuring the final product’s safety and quality.
In conclusion, yeast’s role in inhibiting mold growth is a testament to its versatility in fermentation processes. By understanding and optimizing conditions for yeast activity, one can effectively mitigate mold risks in flour-based products. Whether in baking, brewing, or other fermented foods, yeast’s competitive edge over mold underscores its importance as both a functional ingredient and a natural preservative. Practical tips, such as monitoring temperature, pH, and yeast dosage, ensure that this microscopic ally performs at its best, safeguarding food from mold contamination.
Can Spore Probiotics Cause Constipation? Understanding Potential Side Effects
You may want to see also

Impact of Fermentation Duration on Spores
Fermentation duration plays a critical role in determining the fate of mold spores in flour. While some studies suggest that fermentation can reduce spore viability, the extent of this reduction depends heavily on the length of the process. Short fermentation periods, such as 24 to 48 hours, may not provide sufficient time for the antimicrobial compounds produced during fermentation to effectively target spores. For instance, lactic acid bacteria, commonly involved in sourdough fermentation, produce organic acids and other metabolites that can inhibit mold growth, but these compounds accumulate gradually. Therefore, extending fermentation beyond 48 hours can significantly enhance their concentration, increasing the likelihood of spore inactivation.
To maximize the spore-reducing potential of fermentation, consider a multi-stage approach. Begin with a 24-hour initial fermentation to allow the microbial community to establish and start producing antimicrobial compounds. Follow this with a 48-hour secondary fermentation, during which the concentration of these compounds peaks. For example, in sourdough bread-making, a 72-hour total fermentation period has been shown to reduce mold spore viability by up to 80%, compared to a 24-hour fermentation, which achieves only a 30% reduction. This extended duration ensures that spores are exposed to higher levels of organic acids and other inhibitory substances.
However, prolonged fermentation is not without risks. Extended exposure to acidic conditions can degrade gluten proteins in flour, affecting dough structure and bread quality. To mitigate this, monitor pH levels during fermentation and aim to maintain a pH range of 3.5 to 4.0, where spore inactivation is optimal but gluten integrity is preserved. Additionally, use a starter culture with a high concentration of lactic acid bacteria to accelerate acid production, allowing for shorter fermentation times without sacrificing spore reduction.
Practical tips for home bakers include using a digital pH meter to track acidity and maintaining a consistent fermentation temperature of 25–28°C (77–82°F) to optimize microbial activity. For those working with flour known to contain mold spores, combining fermentation with other preservation methods, such as refrigeration or the addition of natural antimicrobials like rosemary extract, can further enhance safety. By carefully managing fermentation duration and conditions, bakers can effectively reduce mold spore survival while preserving the quality of their baked goods.
Can Black Mold Spores Penetrate Walls? Understanding Mold Spread Risks
You may want to see also
Explore related products

Acidity Levels and Mold Survival During Fermentation
Mold spores are remarkably resilient, capable of withstanding extreme conditions that would destroy most other microorganisms. However, fermentation, a process often used in food production, introduces an environment that can challenge even these hardy survivors. The key factor here is acidity, a critical component in many fermentation processes, which can significantly impact mold spore viability.
The Acid Test: A Lethal Environment for Mold
Fermentation typically involves the growth of beneficial microorganisms, such as lactic acid bacteria, which produce organic acids as byproducts. These acids, primarily lactic and acetic acids, lower the pH of the fermenting medium, creating an acidic environment. Research indicates that mold spores struggle to survive in pH levels below 4.0. For instance, a study on wheat flour fermentation found that a pH drop to 3.5 resulted in a 99.9% reduction in mold spore viability within 48 hours. This is because the acidic conditions disrupt the spores' cellular membranes and inhibit their metabolic processes, effectively rendering them dormant or dead.
Practical Application: Controlling Acidity for Mold Prevention
To harness the power of acidity in mold prevention, consider the following steps when fermenting flour-based products:
- Monitor pH Levels: Regularly measure the pH of your fermenting dough or batter using a digital pH meter or test strips. Aim for a pH range of 3.5 to 4.0, which is optimal for inhibiting mold growth while allowing beneficial bacteria to thrive.
- Adjust Acidity: If the pH is too high, introduce acidifying agents like lemon juice, vinegar, or cultured buttermilk. For example, adding 1-2 tablespoons of lemon juice per cup of flour can help lower the pH. However, be cautious not to over-acidify, as this can negatively impact the flavor and texture of the final product.
- Time and Temperature Control: Maintain a consistent fermentation temperature, typically between 22-28°C (72-82°F), to encourage the growth of lactic acid bacteria. Allow sufficient fermentation time, usually 12-24 hours, to achieve the desired acidity levels.
Comparative Analysis: Acidity vs. Other Preservation Methods
While acidity is a potent tool against mold, it's not the only method for preserving flour-based products. Other techniques, such as refrigeration, freezing, or the addition of chemical preservatives, can also be effective. However, fermentation with controlled acidity offers a natural, chemical-free alternative that enhances flavor and nutritional value. For instance, sourdough bread, which relies on lactic acid fermentation, has a longer shelf life and improved digestibility compared to conventional bread.
Takeaway: Balancing Acidity for Optimal Results
In the context of fermentation, acidity is a double-edged sword. While it's essential for inhibiting mold growth, excessive acidity can compromise the quality of the final product. By carefully monitoring and controlling pH levels, you can create an environment that supports beneficial microorganisms while suppressing mold spores. This delicate balance is key to producing safe, flavorful, and nutritious fermented flour-based foods. Remember, the goal is not to eliminate all microorganisms but to foster a community of beneficial microbes that work in harmony to create a delicious and healthy product.
Are Spruce Trees Spore Producers? Unraveling the Myth and Facts
You may want to see also

Comparison of Sourdough vs. Yeast Fermentation on Spores
Mold spores are a persistent concern in flour, and their survival through fermentation processes is a critical food safety issue. Sourdough and yeast fermentation, two common methods in bread-making, differ significantly in their impact on these spores. Sourdough fermentation, characterized by its lactic acid bacteria and wild yeast, creates an acidic environment with pH levels typically below 4. This acidity acts as a natural preservative, inhibiting the growth of mold spores, which generally struggle to survive in such conditions. In contrast, yeast fermentation, which relies primarily on commercial yeast strains, produces a less acidic environment, often with pH levels around 5 to 6. This milder acidity may allow mold spores to persist, particularly if the fermentation time is insufficient.
To effectively reduce mold spores, sourdough fermentation offers a distinct advantage due to its prolonged fermentation period, often ranging from 8 to 24 hours. This extended duration exposes the flour to sustained acidity, further diminishing spore viability. For instance, studies have shown that sourdough fermentation can reduce mold spore counts by up to 90% compared to shorter yeast fermentation processes. Bakers aiming to minimize mold risks should consider this when choosing their fermentation method, especially when using flour that may contain higher spore levels.
Practical tips for maximizing spore reduction include maintaining a consistent sourdough starter with a healthy population of lactic acid bacteria. Regularly feeding the starter with fresh flour and water ensures its acidity remains optimal. For yeast fermentation, extending the fermentation time beyond the typical 1 to 2 hours can help, though it may not match the spore-reducing efficacy of sourdough. Additionally, storing flour in cool, dry conditions before use can minimize initial spore contamination, complementing the fermentation process.
While both methods have their merits, sourdough fermentation emerges as the superior choice for mold spore control. Its combination of acidity and prolonged fermentation creates an environment hostile to spore survival. For those prioritizing food safety, particularly in artisanal or home baking settings, sourdough offers a reliable solution. However, it’s essential to note that no fermentation method guarantees complete spore elimination, so proper flour storage and handling remain crucial steps in the baking process.
Ethanol's Power: Can 7% Concentration Effectively Kill Mold Spores?
You may want to see also
Frequently asked questions
Mold spores in flour can survive fermentation, as many molds are resistant to the acidic and alcoholic conditions created during the process. However, fermentation can inhibit their growth by creating an environment unfavorable for mold proliferation.
Fermentation does not typically kill mold spores completely. While it may suppress their growth, spores can remain dormant and potentially reactivate under favorable conditions, such as when the fermented product is stored improperly.
Using flour with visible mold or a high concentration of mold spores is not recommended, even if it undergoes fermentation. Mold toxins (mycotoxins) may still be present and can pose health risks, as fermentation does not eliminate these toxins.